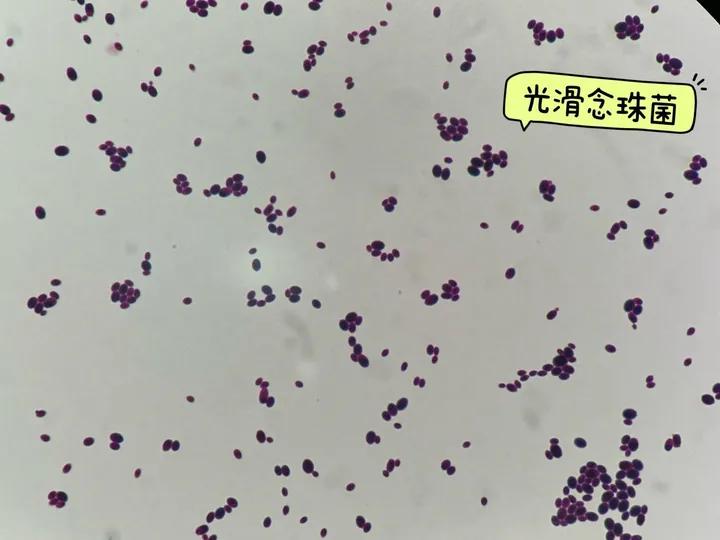
经常穿紧身内裤的坏处,经常穿紧身裤子对身体有影响吗

#霉菌性阴道炎##妇科疾病##阴道炎##紧身裤##化纤##女性健康##女性#

(菌落形态)
充满朝气的绿色
沉稳宁静的蓝色
低调优雅的紫色
温柔可爱的粉色
是不是看着很赏心悦目?
然而这盘并不是令人垂涎的米其林美食
她的真相
却是令千万女性困扰的 *处私**疾病致病菌

是的,正所谓“人不可貌相,海水不可斗量”,真菌也是如此。
上面那让人赏心悦目的照片呈现的便是引起我们女性霉菌性阴道炎的一些重要病原菌—— 绿色(白念珠菌) 、 蓝色(热带念珠菌) 、 紫色(光滑念珠菌) 、 粉色(克柔念珠菌) 。
其中 翡翠样的绿色(白念珠菌) 是罪魁祸首。
【革兰染色显微镜下形态】

什么是霉菌性阴道炎呢?
霉菌性阴道炎也叫真菌性阴道炎、外阴阴道假丝酵母菌病,是由假丝酵母菌引起的常见外阴阴道炎症。80%~90%真菌性阴道炎是由白念珠菌感染引起的,10%~20%由光滑念珠菌、热带念珠菌、克柔念珠菌、*平近**滑念珠菌等引起[1]。
白念珠菌广泛分布于自然界,通常存在于人的体表、口腔、上呼吸道、肠道和阴道黏膜,属机会致病菌,当机体发生正常菌群失调或抵抗力降低时,白念珠菌可侵犯人体多个部位,引起各种念珠菌病。有研究表明,29%~49%女性在其一生中至少有1次急性感染[2]。

哪些人容易患霉菌性阴道炎?
1. 长期使用广谱抗生素患者;
2. 大量应用免疫*制剂抑**以及接受大量雌激素治疗患者;
3. 糖尿病患者;
4. 妊娠妇女;
5. 穿紧身化纤*裤内**;
6. 使用宫内节育器。

霉菌性阴道炎有哪些症状?
1. 外阴阴道瘙痒、阴道分泌物增多;
2. 部分患者有外阴部灼热痛、*交性**痛以及排尿痛;
3. 阴道分泌物为白色稠厚,呈凝乳状或豆腐渣样;
4. 月经前一周,症状和体征可加重。

如何判断是否患有霉菌性阴道炎?
1. 具有典型的分泌物(厚厚的白色豆腐渣样阴道分泌物);
2. 检测阴道PH值<4.5;
3. 在阴道分泌物中找到念珠菌的芽生孢子或假菌丝。

如果症状提示有霉菌性阴道炎,但是湿片法显微镜下未发现念珠菌的成分,则需进行真菌培养。
经常复发者也要通过做培养来证实诊断并排除非白念珠菌。
霉菌性阴道炎如何预防?
1. 注重个人卫生,保持外阴清洁,穿宽松,吸潮的棉质服装,让空气流通,可以使外阴干燥减少真菌生长;
2. 提倡淋浴;
3. 加强体育锻炼,提高自身免疫力;
4. 饮食均衡,少吃甜食;

霉菌性阴道炎该怎样治疗?
女性朋友如果发现有相关症状时,切勿自己胡乱用药,及时到正规医院就诊。消除诱因,遵循医嘱,根据具体情况选择局部或全身抗真菌药物,多以局部用药为主。

参考文献:[1] 谢幸, 孔北华, 段涛.妇产科学[M].北京:人民卫生出版社,2018,241-243.[2] 李婷, 刘朝晖. 2020年美国妇产科医师学会《非妊娠期阴道炎》管理指南解读[J]. 中国实用妇科与产科杂志, 2021,37(2):205-207.
▌本文科普主题来源于《协和医学杂志》2023年5期“微生物与免疫”《基于多尺度注意力机制的真菌显微图像分类方法》

编辑 丨刘洋 赵娜
审校 丨李娜 李玉乐 董哲 李慧文
监制 丨吴文铭
【版权声明】 《协和医学杂志》倡导尊重和保护知识产权,欢迎转载、引用,但需取得本平台授权。如您对文章内容及版权存疑,请发送邮件至medj@pumch.cn,我们会与您及时沟通处理。图文内容仅供交流、学习使用,不以盈利为目的;科普内容仅用于大众健康知识普及,读者切勿作为个体诊疗根据,自行处置,以免延误治疗。治病就医相关需求请于北京协和医院APP线上或线下就诊。